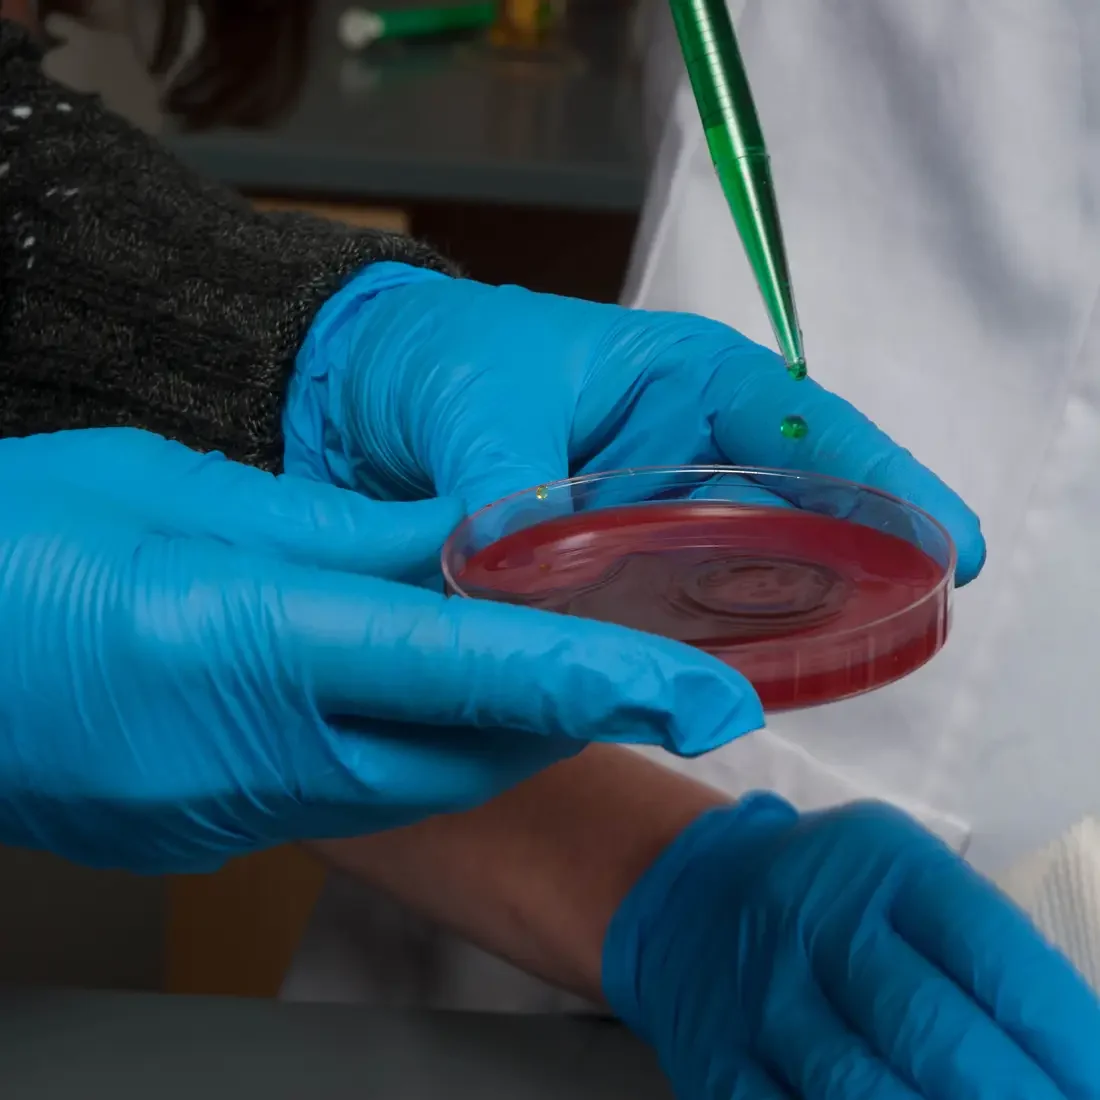
Biology 0519

There are many idealized versions of what scientific research looks like. It usually involves clean cut methods that work on the first try, and provide unquestionable data. This romanticized version of laboratory work is rarely realized. I am a fourth year Ph.D. student at Idaho State University-Meridian. As someone who has spent nearly 10 years in laboratories, I would say that I am a skilled technician capable of performing several assays without problems or guidance. However, even with this skillset I have still spent the summer repeating work, modifying procedures and trying again.
This repeating of work can be extremely frustrating, but it’s at the heart of what science is. Unlocking the knowledge of the underlying principles of a biological phenomenon is always gratifying and can create new tools that can improve life for everyone. But science is so much more than the answer. It is the pursuit of the answer that is fun and intriguing. It’s trying to solve the problem that makes the solution so rewarding.
I write this, sitting in the laboratory waiting for yet another electrophoresis gel to separate out my results and tell me if my 4th attempt at PCR actually worked. My lab notebook reads similarly: Ran experiment again, results: inconclusive, attempt again. This is nothing new, I spent 8 months of my second year in the program working out the kinks on an assay that is sold as a kit and should work right out of the box. Two years later, I can use this assay without problem and am presenting data from these experiments at a conference next week. But it’s not the endless weekends of work, or the data generated I remember. It’s the solving of the riddle. It’s the possibility that by working out the details of these assays, I have uncovered the key to my bigger hypothesis that has given me so much satisfaction.
All of this reminds me of the old saying: “If it’s not hard, it’s not worth doing”. So often in life we shy away from hard things. We put them at the bottom of our to-do list or avoid them entirely. I wonder if we all approached life, school, work as if we are in a laboratory and focused on the process and less on the results, if we would feel more rewarded at the end.
So here I sit, waiting for my gel and wondering if I will be re-doing my research tomorrow, but not forgetting that the joy in research comes not only from the solution, but in learning how to solve the problem.